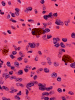

T1+Contrast






GFAP
GFAP
Fontana-Masson



Iron
PAS
| A 20 year-old Woman with a
Large Cystic Right Ventricular Mass. December, 2008, Case 812-1. Home Page |
Charles Beavers (MS-IV)1, Kar-Ming Fung, M.D., Ph.D.2 Last update: December 26, 2008.
1 College of Medicine and 2 Department of Pathology, University of Oklahoma Health Sciences Center, Oklahoma City, Oklahoma
Clinical information: The patient was a 20 year-old woman who was about 5 weeks postpartum. She presented with nausea, vomiting, and severe headache. MRI scan revealed a large cystic right ventricular tumor with extension to the right parietal occipital area but the main bulk of the tumor is within the lateral ventricle. The cystic component, however, extends to the cortical rim of the parietal occipital cortical region. Some calcifications are present. The differential diagnosis include choroid plexus tumor and intra-axial glial neoplasm. The tumor was resected and the following images are representative of the tumor.

|

|

|

|

|

|
|
A. T1+Contrast |
B. | C. | D. | E. | F. |

|
|

|

|

|

|
| G. | H. | I. |
J. GFAP |
K. GFAP |
L. Fontana-Masson |

|
 |
 |
|||
|
M. Iron |
N. PAS |
Scanned slide |
Pathology of the Case: MRI shows a large mass with the more solid component located in the lateral ventricles and the cystic component protruding into the cortical area. The solid area is enhanced (Panel A). On low magnification, the lesion has alternating area of high and low cellularity (Panel B) with scattered calcifications in some of the sections. Medium and high magnification demonstrates perivascular coronary arrangement of cytoplasmic processes (Panel C, D, and E). The nuclei are bland and mitotic figures are not readily seen. Randomly scattered brown pigment containing cells are found in multiple areas of the tumor (Panel F, G, and H). Scant lipidized cells with enlarged nuclei (Panel I) are also present. The tumor cells are strongly positive for glial fibrillary acidic protein (GFAP) (Panel J and K) and S100 protein but are negative for epithelial membrane antigen (EMA), neurofilament proteins, and NeuN. The overall Ki67 labeling is low but focal small areas (about the size of one high power field) has increased labeling. The pigment appears to be melanin on microscopic examination. These pigments are positive with Fontana-Masson stain (Panel L) but negative for Prussian blue stain for iron (Panel M). These features confirmed that these are melanin pigments. The pigment granules are positive for periodic acid-Schiff reaction (N), negative for Ziehl-Neelsen (acid fast) stain..
| DIAGNOSIS: Ependymoma, WHO grade II, pigmented. |
Discussion:
General Information
Ependymoma is a relative uncommon tumor of the central nervous system (CNS). It represents about 5-7% of all brain tumors regardless of the age and about 10% of brain tumors in children. They typically arises from anatomical locations that have a ependymal linings and occur in a descending order of frequency in fourth ventricle, lateral ventricle, third ventricle, aqueduct, spinal cord, cauda equina, extraventricular hemisphere. Hydrocephalus and spinal dissemination is not an uncommon finding. The 5-, 10-, and 15-year overall survival rates were 71.4%, 63.5%, and 63.5% for craniospinal radiotherapy. Its association with neurofibromatosis 2 has been well documented.
Infratentorial ependymomas are more common in children and occur predominantly within the first two decades of life. About 30% of intracranial tumors in children under 3 years of age are ependymomas. Supratentorial ependymomas are equally common among adults and children. Ependymomas of the spinal cord are more frequently seen in adults. These tumors may grow into as an exophytic mass in the 4th ventricles or invade the adjacent brain tissue. CT scan usually shows a well demarcated, heterogeneous, and hyperdense mass with uniform contrast enhancement. Calcifications and some cystic change are common in supratentorial tumors, but less so in infratentorial.
Pathology
Gross tumor in the fourth ventricle is noted to usually be grayish-pink, firm, and cauliflower-like growths. Most of them are sharply demarcated. Tumor in the lateral ventricle may be several centimeters in diameter, reddish-gray, softer, non-encapsulated, and more clearly demarcated from adjacent tissue than astrocytomas. Ependymoma arising in the 4th ventricle may protrude through the foramens of Luschka, Magendie, and then downward through foramen magnum, resulting in caudal tongue-like projections of tumor which compress dorsal and lateral aspects of the upper cervical cord (so called "plastic ependymoma"). Due to its strategic location, hydrocephalus and symptoms referring to the compression of upper cervical spinal cord is not uncommon.
Microscopically, the histology of ependymoma can be quite variable and be easily confused with other gliomas. In essence, there are three major histologic features in ependymoma and most tumors contain a mixed features. The four features are perivascular radial arrangement of epdnymomal cells, isomorphic nuclei, ependymal rosettes or ependymal canals.
The diagnostic pattern of ependymoma is best visualized with very low magnification under the microscope. Similar to astrocytomas, the cytoplasm membrane cannot be discerned. The cells are poor in cytoplasm and the perivascular cell processes taper to a point around the blood vessels. Nuclear-free mantles form cuff like spaces around the vessels is an important diagnostic feature. These structures are also known as pseudorosettes. The cellularity in the cellular can be quite variable. The thickness of the perivascular paucinuclear zone can also be quite variable. As a result, they may be mistaken as astrocytoma easily and in the case of pediatric brain tumors as pilocytic astrocytomas.
Ependymal rosettes are tiny lumina spaces lined by epithelial-like cells. These tumor cells blend imperceptibly with the surrounding tumor cells. Although highly characteristics, ependymal rosettes are quite uncommon and are typically found in infratentorial tumors. When they are slightly larger, they may be called ependymal canals. It is important to not that these rosettes or canals do not have any basement membrane, a key feature not to mistaken these structures as metastatic carcinomas.
Variants of ependymomas include papillary ependymoma, clear cell ependymoma, and tanycytic ependymoma. In particular, papillary may mimic choroid plexus papilloma. Their juxtaventricular location and occurrence in pediatric age group further the confusion. The key feature is that choroid plexus papilloma has basement membrane and papillary ependymomas do not have basement membrane.
Immunohistochemistry
Ependymomas often display significant amount of immunopositivity for glial fibrillary acidic protein (GFAP). They are often but not always positive for epithelial antigen (EMA). The lumninal surface of ependymal rosettes can be strongly positive for epithelial membrane antigen. The same is true for the surface of papillary ependymal ependymoma. EMA positive reaction can also occur as positive dots in tumor cells. The staining can have a cluster pattern of distribution. However, most tumors are only focally positive.
Melanocytic Cells
Although rare in the tumors of the CNS and peripheral nervous system, pigmented/melanonic differentiation have been described in meningioma, neurofibroma, schwannoma, paraganglioma, medulloblastoma, ganglioma of pineal gland, choroid plexus papilloma, pilocytic astrocytoma, pleomorphic xanthoastrocytoma, and ependymomas. These tumors should not be confused with the more common meningeal melanocytic tumor or metastastatic malignant melanomas. Pigmented cells in a primary neuroepithelial tumor comes from two source. The first is due to the formation of neuromelanin. In the normal brain, some neurons consistently form melanin and the pigmented neurons in the substantia nigra are the classic examples. Neuromelanin are positive with Fontana-Masson stain and they could be bleached. They can be positive for periodic acid-Schiff (PAS) reaction and Ziehl Neelsen stain (acid fast stain). However, they are negative for immunohistochemical markers for melanosomes such as HMB45. At the ultrastructural level, no genuine melasomes are found.
The second source of pigment cells are from pigment meningothelial cells being entrapped within the tumor. The term melanocytic colonization is appropriate for this condition. [click here to see a case] In contrast to neuromelanin, the pigments are negative for PAS stain and Ziehl Neelsen stain. In addition, they are positive for immunohistochemical markers such as HMB45.
Lipofusin can appear quite dark and mimic melanin pigment of both types. However, they are positive of Ziehl Neelsen stain and sometimes positive for both PAS and Fontana-Masson stain. However, they are less likely to be bleached. Immunohistochemical markers such as HMB45 would not label these pigments.
Further Reading:
Paulino AC, Wen BC, Buatti JM, Hussey DH, Zhen WK, Mayr NA, Menezes AH. Intracranial ependymomas: an analysis of prognostic factors and patterns of failure. Am J Clin Oncol. 2002 Apr;25(2):117-22.